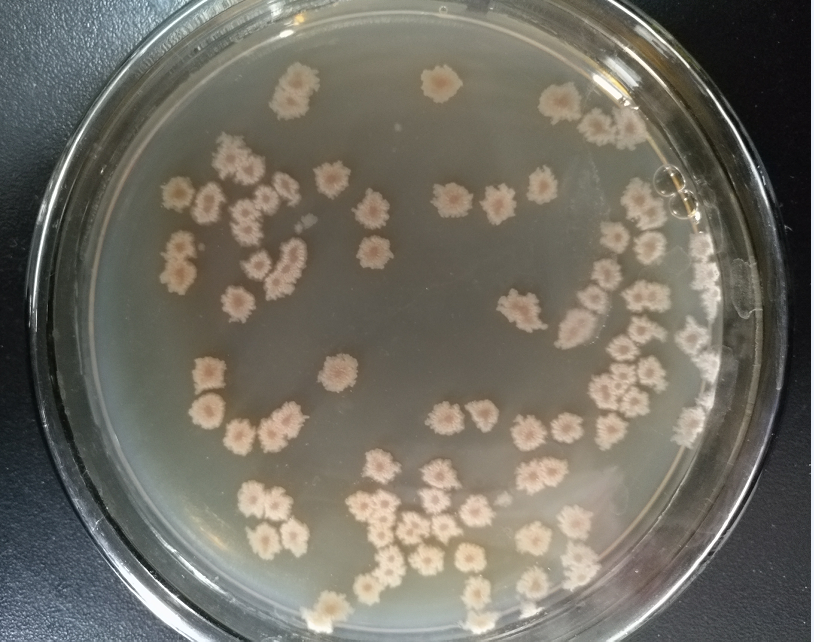
窖泥功能菌

老永利官网
联系人:陆奉勇
电 话:0531-87483989
手 机:13905416779
邮 编:250308
网址:
地 址:山东省济南市长清区张夏工业园区
中国青年网北京3月2日电(人民政协报记者 林仪 王惠兵)今年“两会”,不少新词、新领域引起了人们的关注。微生物,与农业、气候、环境乃至人类健康息息相关。全国政协常委、福建省政协副主席陈绍军提出,要抢占微生物领域的高地,抓紧制定并实施“中国微生物战略2030”,用十多年的时间,使我国的微生物研究和产业化运用达到世界先进水平。

今年,陈绍军向全国政协提交了《建议抓紧制定并实施微生物2030国家战略》提案。他举例说明了微生物的重要性。如在农业方面,微生物在提高土壤肥力、改进作物特性、促进粮食增产、防治粮食作物的病虫害、防止粮食霉腐变质,以及把多余粮食转化为糖、单细胞蛋白、各种饮料和调味品等方面,都可大显身手。在能源方面,微生物可以把自然界蕴藏量极其丰富的纤维素转化成乙醇。在生物化工方面,微生物又能将纤维素等可再生资源转化成各种化工、轻工和制药等工业原料。在医药健康领域,如SARS、流感等疾病,各种药物、抗生素、疫苗、激素、基因疗法等,更与微生物密切相关。
当前,发达国家对微生物领域都给予了高度关注。自2005年以来,国际科学界开展了至少8项人体微生物组计划,包括美国人类微生物组项目、加拿大微生物组研究项目以及日本人体元基因组项目。2016年5月,美国宣布启动“国家微生物组计划”,开展投资和研发,其所带动的产业产值很可能在数千亿美元之上,并由此吸引相关大数据、人才、研发力量的聚集。“ 而我国与微生物相关的多个学科和部门,相互之间协调联系不够,尚未形成合力。”对此,陈绍军表示十分着急。
他建议加强微生物领域的基础科研,在微生物药物研发、生物能源转化、生物肥料与农药研制、食品添加剂改良、水土净化与改良、垃圾分解等领域,加大投入,鼓励创新,形成一批可推广的成果,推动重点领域的研发和产业化进程。
他指出,要把微生物资源作为国家重要战略性资源,将微生物安全作为国家安全的一个重要基础。我国应发挥各方面优势,制定规划,加快率先利用全球微生物资源。同时结合“一带一路”、亚投行等战略,积极推动微生物领域国际合作,推广中国标准、实施中国方案,占据国际微生物科研和产业的制高点。
